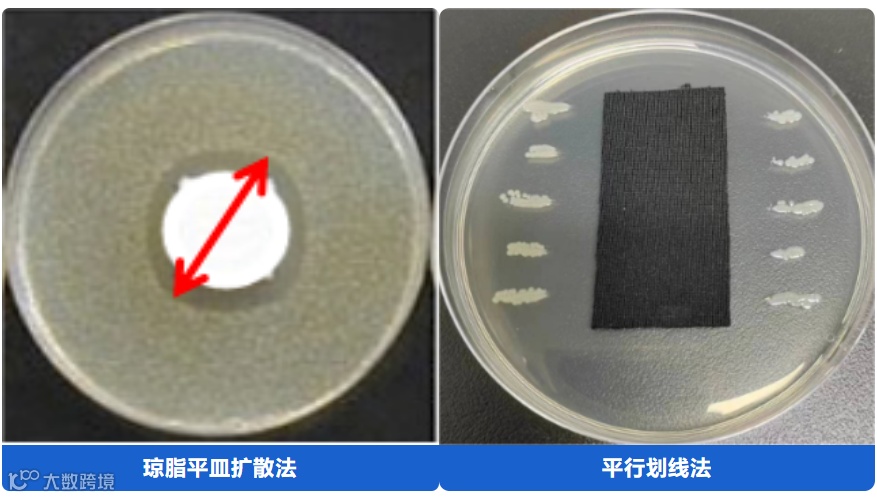

随着人们生活水平的提高,对纺织品抗菌抑菌功能性的需求也日益增强,越来越多的抗菌面料、抗菌纺织产品应运而生。针对这一特殊的功能性我们怎么进行测试?你的抗菌面料测试方法选对了吗?下面我们从抗菌性能测试分类、测试原理、效果评价等方面具体探究一下。
纺织品抗菌性能测试方法繁多,主要可分为两大类,定性测试和定量测试。
常用、有代表性的测试标准
测试原理
将抗菌样品紧贴在接种一定量特定微生物的琼脂平板表面,经过一段时间的接触培养后,观察样品周围有无抑菌区以及样品与琼脂的接触面有无微生物生长,以此来判断样品是否具有抗菌性能。
定性测试适合判定产品有无抗菌效果,当样品周围有抑菌区或样品与培养基接触表面没有细菌生长时,说明该样品具有抗菌性能,但不能通过抑菌区的大小去判断纺织品抗菌活性的强弱。抑菌区的大小可以体现抗菌产品所采用抗菌剂的溶出性。
常用、有代表性的测试标准
测试原理
经过抗菌处理的样品和没有经过抗菌处理的对照样品定量接种测试菌悬液后,经过一定时间的培育,通过对比抗菌测试样品和对照样品中细菌生长数量,定量评价纺织品的抗菌效果。在定量检测法中,常用的方法有吸收法和振荡法。
吸收法是对照样品和抗菌测试样品吸收一定量的菌悬液,在静置的状态进行培养,一定时间后把样品上的测试菌洗脱下来进行检测比对,从而评价其抗菌性能,适用于有一定吸水性的抗菌织物的抗菌性能测试。
振荡法是将对照样品和抗菌测试样品完全浸泡在含一定浓度范围测试菌液的缓冲液中,持续振荡培养,一定时间后对菌液进行检测比对,适用于非溶出性抗菌纺织品和吸水性差的样品的抗菌性能测试。
效果评价
定量测试方法以抑菌率或抑菌值这种百分比或数值的形式体现抗菌纺织品抗菌活性的高低,抑菌率、抑菌值越大表示抗菌效果越好。部分测试标准给出了相应的效果评价依据。
现在您知道抗菌测试方法如何选择了吗?可以综合考虑以下三点:
测试需求
只想知道有没有抗菌效果——选择定性测试即可
想知道抗菌效果好不好——选择定量测试
需要评级——选择可以评级的标准(例如上图)
产品特性
非溶出性抗菌纺织品和吸水性差的样品,首选振荡法。
产品用途或企标要求
例如产品宣称对标准以外的菌种具有抗菌效果,则需要增加该菌种测试。
温馨提醒
抗菌功能性纺织品的测试不仅仅有抗菌性能,更有安全性能的要求,溶出性测试就是其安全性能中的一项指标。我们的抗菌纺织品大多接触人体,它们首先应该是安全的,然后才是抗菌有效的,大家不要忽视了溶出性这一重要指标哦!
供稿:中纺联检(江苏)余蕊


